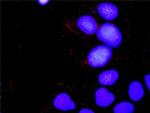
CRKL Antibody in Proximity Ligation Assay (PLA) (PLA)

Search
Abnova
CRKL Polyclonal Antibody, MaxPab™
{{$productOrderCtrl.translations['antibody.pdp.commerceCard.promotion.promotions']}}
{{$productOrderCtrl.translations['antibody.pdp.commerceCard.promotion.viewpromo']}}
{{$productOrderCtrl.translations['antibody.pdp.commerceCard.promotion.promocode']}}: {{promo.promoCode}} {{promo.promoTitle}} {{promo.promoDescription}}. {{$productOrderCtrl.translations['antibody.pdp.commerceCard.promotion.learnmore']}}
产品信息
H00001399-D01P
宿主/亚型
分类
类型
抗原
偶联物
形式
浓度
规格
保存条件
运输条件
产品详细信息
Sequence of this protein is as follows: MSSARFDSSD RSAWYMGPVS RQEAQTRLQG QRHGMFLVRD SSTCPGDYVL SVSENSRVSH YIINSLPNRR FKIGDQEFDH LPALLEFYKI HYLDTTTLIE PAPRYPSPPM GSVSAPNLPT AEDNLEYVRT LYDFPGNDAE DLPFKKGEIL VIIEKPEEQW WSARNKDGRV GMIPVPYVEK LVRSSPHGKH GNRNSNSYGI PEPAHAYAQP QTTTPLPAVS GSPGAAITPL PSTQNGPVFA KAIQKRVPCA YDKTALALEV GDIVKVTRMN INGQWEGEVN GRKGLFPFTH VKIFDPQNPD ENE
靶标信息
The CRKL gene encodes the CRK-like protein, an adaptor protein that plays a crucial role in intracellular signaling pathways related to cell proliferation, differentiation, and migration. CRKL contains SH2 and SH3 domains that facilitate interactions with other signaling molecules, influencing multiple pathways such as the MAPK, PI3K, and STAT pathways. It is involved in processes like cytoskeleton reorganization and immune cell signaling, with significant implications for development and cancer. CRKL is notably associated with Philadelphia chromosome-positive leukemias, where it interacts with the BCR-ABL fusion protein, contributing to leukemogenesis. Additionally, dysregulation of CRKL can affect cardiovascular development, leading to congenital heart defects. Research into CRKL focuses on understanding its role in signal transduction and its potential as a therapeutic target due to its involvement in oncogenic and developmental pathways.
仅用于科研。不用于诊断过程。未经明确授权不得转售。